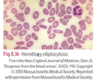

haemolytic anaemia Flashcards
(38 cards)
definition of haemolytic anaemia
Premature erythrocyte breakdown causing shortened erythrocyte life span (<120 days) and anaemia
classifications of causes of haemolytic anaemia
hereditory
- membrane defecys
- metabolic defects
- haemoglobinopathies
acquired
- autoimmune
- isoimmune
- drugs
- trauma
- infection
- paroxysmal nocturnal haemoglobinuria
hereditory membrane defects = haemolytic anaemia
hereditory spherocytosis
elliptocytosis (elliptical erythrocytes)
hereditory ovalocytosis
hereditory stomatocytosis
hereditory spherocytosis
autosomal dominant
coombs -ve
prevalence 1:3000
low spectrin (structural membrane protein) = low deformability of spherical erythrocytes
= trapped in spleen
= extravascular haemolysis
signs - splenomegaly and jaundice
hereditory metabolic causes of haemolytic anaemia
ie enzyme defects
- G6PD deficiency
- pyruvate kinase deficiency - autosomal recessive
G6PD deficiency
X linked
affects 100million mainly men in Mediterranean, Africa, middle/far east
G6PD is important in maintaining glutathione in reduced state.
most asymptomatic
Deficiency results in susceptibility to oxidative stress (e.g. precipitated by sulphonamides, nitrofurantoin, primaquine, aspirin, dapsone, vicia faba - fava beans/favism, illness).
in severe oxidative attacks = rapid anaemia and jaundice
hereditory haemoglobinopathies that = haemolytic anaemia
sickle cell disease
thalassaemia
acquired autoimmune causes of haemolytic anaemia
warm or cold Ab attach to erythrocytes = intravascular and extravascular haemolysis
Warm’ antibodies (IgG) agglutinate erythrocytes at 37 ̊C.
- Associated with SLE, lymphomas or methyldopa.
‘Cold’ antibodies (IgM) agglutinate erythrocytes in at room temperature or colder.
- Associated with infections (e.g. Mycoplasma, EBV) or lymphomas.
isoimmune causes of haemolytic anaemia
transfusion reaction
haemolytic disease of the newborn
drug causes of haemolytic anaemia
penicillin
quinine (through formation of drug–antibody–erythrocyte complex).
trauma causes of haemolytic anaemia
microangiopathic haemolytic anaemia caused by red cell fragmentation in abormal microcirculation eg:
- haemolytic uraemic syndrome,
- TTP
- DIC,
- malignant hypertension,
- pre-eclampsia and eclampsia
- artificial heart valves
= intravascular haemolysis and schistocytes
infection causes of haemolytic anaemia
malaria - RBC lysis and blackwater fever (haemoglobinuria)
sepsis
all infections can exacerbate haemolysis
paroxysmal nocturnal haemoglobinuria
increased complement-mediated lysis caused by reduced synthesis of protein cellular anchor of complement degrading proteins
rare acquired stem cell disorder, with haemolysis (especially at night -> haemoglobinuria), marrow failure and thrombophilia
epidemiology of haemolytic anaemia
common
Genetic causes are prevalent in African, Mediterranean, Middle Eastern populations.
Hereditary spherocytosis is the most common inherited haemolytic anaemia in northern Europe.
sx of haemolytic anaemia
jaundice
haematuria, dark urine
anaemia
ask about: systemic illness, FHx Dx, travel Hx, race
signs of haemolytic anaemia
pallor - anaemia
jaundice
hepatosplenomegaly
pigmented gallstones due to bigh BR from haemolysis
leg ulcers - poor blood flow
Ix for haemolytic anaemia
blood
blood film
urine
direct antiglobin Coombs test (DAT)
Osmotic fragility test or Spectrin mutation analysis - to identify membrane abnormalities.
Ham’s test
Hb electrophoresis or enzyme assays - when other causes excluded
bone marrow biopsy (rarely required) - erythroid hyperplasia
blood results for haemolytic anaemia
FBC - low Hb and haptoglobin, high reticulocytes, MCV and unconjugated BR
UE
folate
haptoglobin
mop for free Hb
lowers in intravascular haemolysis
blood film in haemolytic anaemia
leucoerythroblastic picture
macrocytosis
nucleated erythrocytes or reticulocytes,
polychromasia
spherocytes - hereditory spherocytosis or autoimmune haemolytic anaemia
elliptocytes - hereditory eliptocytosis
sickle cells - SCD
hypochromic microcytic anaemia - thalassaemia
fragmented erythrocytes (schistocytes) - MAHA
malarial parasites,
erythrocyte Heinz bodies (denatured Hb, stained with methyl violet seen in G6PD deficiency).
abnormal cells in malignancy
urine results in haemolytic anaemia
raised urobilirubin
If intravascular haemolysis = haemoglobinuria, haemsiderinuria
direct coombs’ test
identifies erythrocyte coated with antibodies (agglutins) or complement using antihuman globulin
warm agglutin and cold agglutin
indicates immune cause
Ham’s test
lysis of erythrocytes in acidified serum in paroxysmal nocturnal haemoglobinuria
More recently – red cells are analyzed, using monoclonal antibodies to the GPI-anchored proteins (CD55 and CD59) and flow cytometry.
haemolytic anaemia summary
may be normocytic
if a lot of young RBC and reticulocytes = macrocytic
suspect if
- reticulocytosis >2% of RBCs. or reticulocyte count >100x10(9)/L
- mild macrocytosis
- low haptoglobin
- high BR
- high LDH
- high urobilinogen
often mild jaundice (pre-hepatic, so no BR in urine)